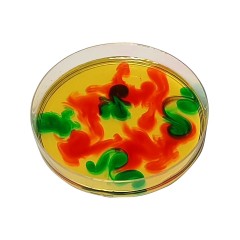
myExperimentSet Forschen und Experimentieren zu Dichte und Farben Исследования и эксперименты с плотностью и цветами

Популярные товары
CHANEL Rouge Allure Laque Стойкая, блестящая жидкая помада, тон 167 ROUGE NOIR, Коллекция 2026 года «Руж Нуар» ограниченный выпуск13 500 ₽
Modu Dreamer Kit 34-teilig sand grey/yellow honey, Мягкий конструктор MODU Dreamer Set 34 детали, 25 моделей, безопасная развивающая игрушка для детей 2-6 лет из EPP, Песочно-серый/медово-желтый43 995 ₽
SodaStream 7UP Sirup 3stk, Сироп для приготовления 7UP, без сахара, 440 мл х 3 штуки2 788 ₽
Поиск по запросу
Diskontshop предлагает лучшие товары и новинки бренда myExperimentSet. Приобретая товары в Германии, Вы можете быть уверены в оригинальном качестве продукции и надёжности доставки
12/24/36/48
Дата добавления